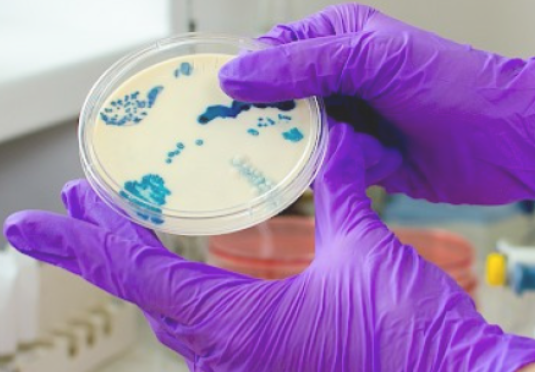
Imagen

Laboratorio Clínico Candelaria
Carr. 863 km 0.6 Bo. Pájaros, Toa Baja Cómo llegar
Realizamos la mayoría de las pruebas de laboratorio.

Detalles
El Laboratorio Clínico Candelaria ofrece servicios profesionales de la más alta calidad respetando y protegiendo la privacidad de nuestros pacientes. Nuestro compromiso es con la familia puertorriqueñ
Productos y servicios
- Pruebas para Matrimonio
- Pruebas de Embarazo
- Pruebas de Dopaje Ver más ...
Información
Horario
Sábado
07:00 am - 12:00 pm
Redes Sociales
Formas de pago
Cobertura
Este cliente cuenta con las siguientes áreas de Servicio y Cobertura Adicional en Puerto Rico





